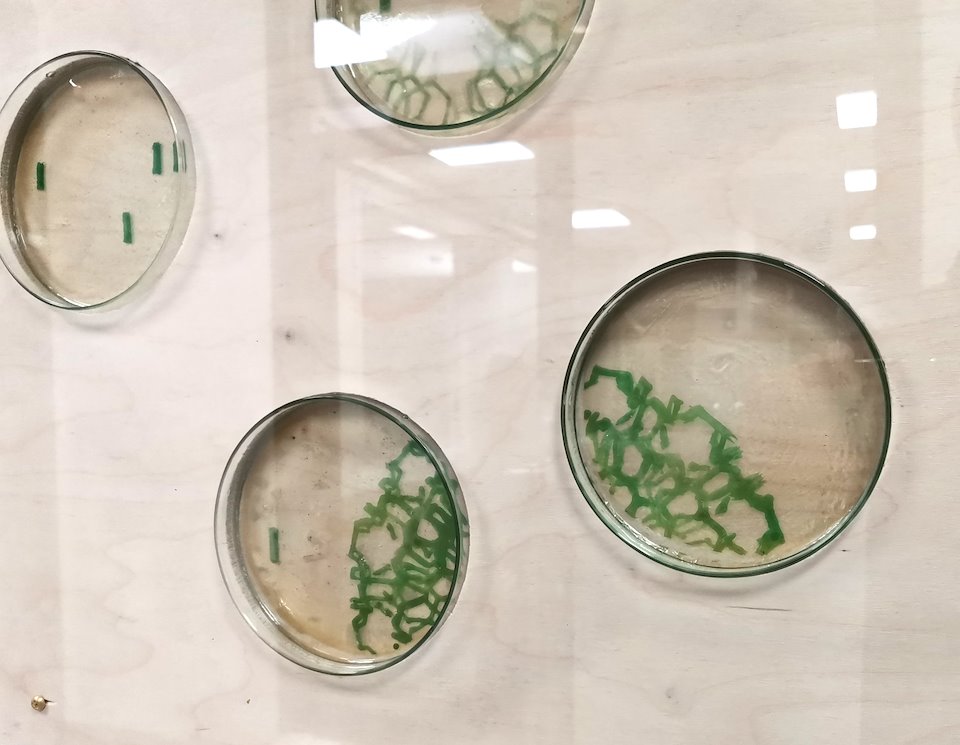

2021
Year 2021 was special for my art. My precious genemusic chimed thru organs and speakers during summertime in public places and at the opening of Organ Festival of Lahti. Bioart-project of mine got ready and was hanged on to the walls of The new Hospital of Kainuu. I was also interviewed to Naturevolve art-science magazine. The science and physical phenomenas in my art could be seen and heard in many ways.
Our blue planet made me search ecofriendlier ways to make art. I started to make eggtempera-paintings on clayplaster, I burned biochar to make my own carbonsink. Another year of Covid made me think more about nature and less about human.



Genemusic ODEINCODE from speakers in LAHTI MALVA MUSEUM at Public ART Exhibition
Bioart-installation at New Hospital of Kainuu


Interview in NATUREVOLVE about my bioart and soundart-projects.
https://issuu.com/naturevolve/docs/naturevolve_issue_9/s/12190026